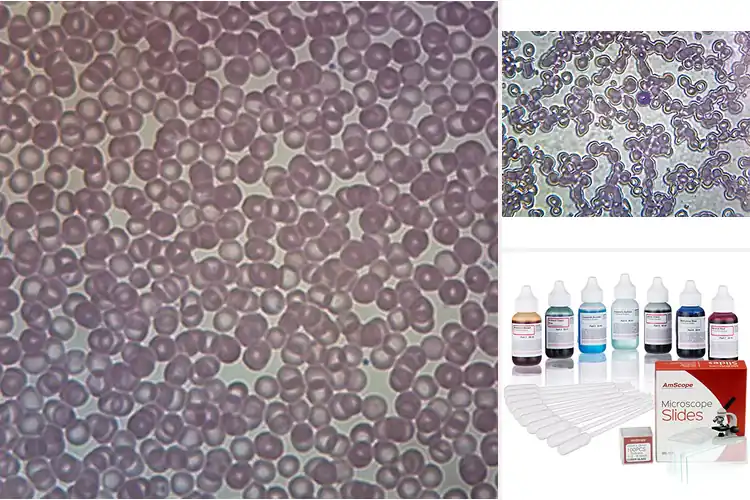
Detailed view of Best Medical Microscope Slides For Anemia

Best Medical Microscope Slides For Anemia
Looking for the best medical microscope slides to study anemia? Discover high-quality slides that provide clear, detailed views of blood cells, helping you understand anemia and build confidence in your studies. Exploring anemia through microscope slides is a fascinating way to learn about this common condition. These slides offer a clear view of blood cells, … Read more